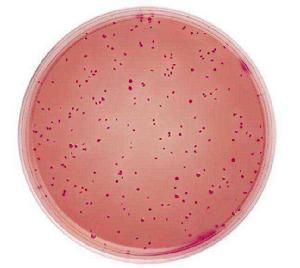
腸菌群最近似數 腸菌群最近似數

定義
腸菌群最近似數是指100g或100ml食品中的大腸菌群的可能數。
簡稱大腸菌群指數或大腸菌值。
一般採用乳糖發酵法,檢驗結果相當於100 g 或100 ml食品中大腸菌群的近似數。
單位:個/100g ,個/100ml
套用
我國現行的食品衛生標準,已在很多食品中將菌落總數和大腸菌群作為微生物的常規指標。
一般在食品安全檢測中,大腸桿菌常用作一種指示菌,具體來講,很多致病菌常常與大腸桿菌一起在食品中繁殖,檢測大腸桿菌可以間接反映食品微生物污染狀況,如果大腸桿菌超標,理論上認為該食品被其他致病菌污染的機率增大;另一方面,有些大腸桿菌,如出血性大腸桿菌本身也是一種致病菌需要監測;再者,如果監測農產品中尤其是表面大腸桿菌的,可以作為該產品是否被糞便污染的指標之一。
腸菌群最近似數的檢測,有利於控制腸道傳染病的發生和流行,判斷食品中是否受到糞便污染,也反應了食品在生產、加工、運輸、儲存等過程中的衛生狀況。
檢測中應注意的問題
1、選擇正確的稀釋度;
2、培養時間要在範圍之內,培養時間過短或過長都會影響發酵管數 ;
3、確證實驗要嚴謹。